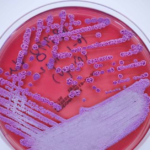
Deadly bacteria that causes meliodosis detected in Mississippi water, CDC reveals First time cause of disease similar to TB has ever been found in the US

- Professor Susan Michie appointed chair of WHO’s behavioural advisory group
- Will advise how to boost compliance with health policies like vaccine rollouts
- She was nicknamed Stalin’s nanny by friends at university for her radical views
A British communist scientist who wanted face masks to be worn forever has been handed an influential role at the World Health Organization.
Professor Susan Michie — a longstanding member of the Communist Party of Britain and Labour donor — was yesterday made chair of the WHO’s behavioural advisory group.
She will advise the organisation on how to boost compliance with vaccine rollouts and other interventions that help shape national health policy.
Her appointment raised eyebrows on social media, given Professor Michie’s hardline views during the Covid pandemic.
She famously called for masks and social distancing to remain ‘forever’ in an interview with Channel 5 last year and regularly spouted alarmist predictions on BBC News, which sparked questions about the broadcaster’s objectivity.
There were concerns about her conflict of interests when it emerged she was simultaneously a member on the Government’s SAGE committee and a leading figure in an independent pressure group that called for Chinese-style lockdowns.
Ms Michie was said to have been nicknamed ‘Stalin’s nanny’ by her contemporaries at Oxford University because of her radical views.

Professor Susan Michie — a longstanding Communist Party member and Labour donour — has been appointed chair of the WHO’s behavioural advisory group

The appointment was announced on Twitter on Monday by University College London’s psychology department, where she is a professor. The news was met with a mixture of fury and astonishment